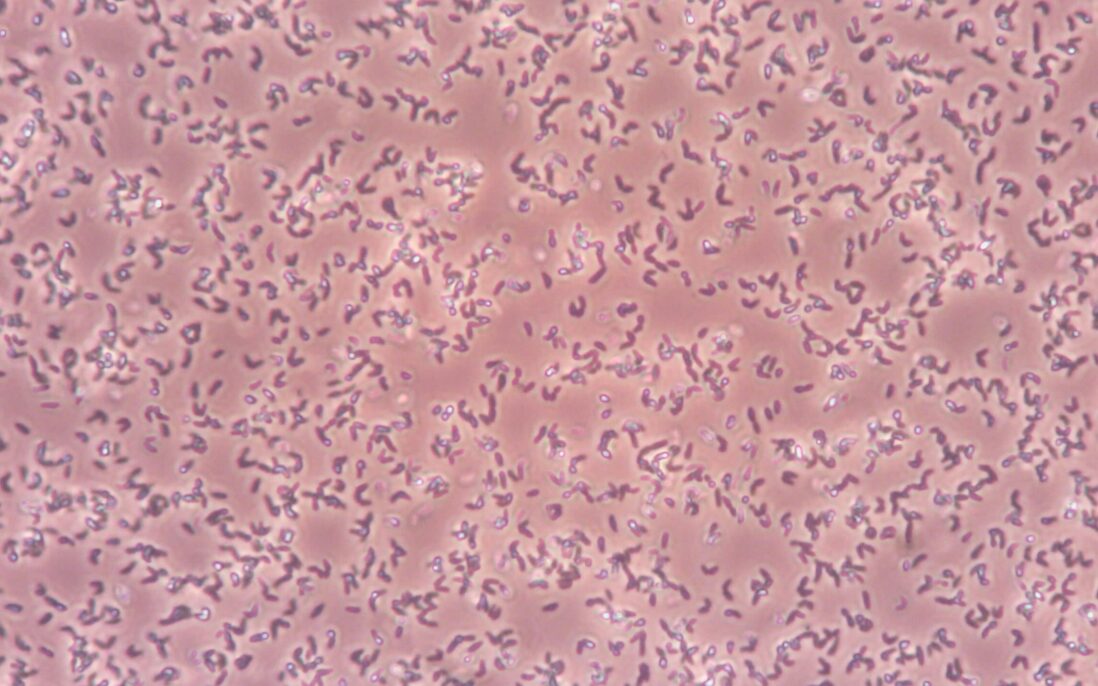
Mikroskopbilde av den aminosyreproduserende mikroorganismen Corynebacterium glutamicum under dyrkning i et medium som inneholder hydrolysert mesk.

Mesk er restene av malten (kornet) fra ølbrygging. Den er tilgjengelig i enorme mengder og brukes i dag til å fôre storfe, til mel og som gjødsel. Mesk inneholder mye protein, og det er dette som gjør den interessant som råvare i mat eller fôr. Den inneholder imidlertid også lignin, cellulose og hemicellulose, som ikke er så bra for fiskens fordøyelse.
- Vi tar sikte på å forvandle mesken til et høyverdig produkt som oppfyller ernæringskravene til fisk. Vårt hovedmål var å lage en oversikt over ulike metoder som kan bidra til å forenkle bruken av mesk som ingrediens i vannfôr. Men dette er ikke helt ukomplisert. Før mesken kan brukes som proteinkilde, må cellulose-, hemicellulose- og ligninfraksjonene fjernes da de ernæringsmessig sett vil ha en negativ påvirkning på fisken. Dette kan gjøres ved å bruke en kombinasjon av kjemiske og biologiske behandlinger, forklarer NORCE-forsker Freja Karlsen.
SUREAQUA er et tverrfaglig senter som leverer forskning og innovasjon for bærekraftig produksjon og forvaltning av ressurser i havet. Som en del av dette samarbeidet fullførte Karlsen et doktorgradsprosjekt ved Danmarks Tekniske Universitet der hun studere muligheten for å utvikle et bærekraftig mesk-basert produkt som kan inngå i fiskefôr.